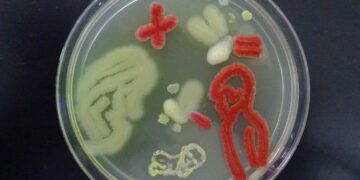
The Cholesterol Cure Found In Your Gut

Health
You can add some category description here.
They also help lower heart disease risk. Recent research suggests that gut bacteria may play a role in determining a...
Read moreStay away from this mix. A recent report reveals a correlation between sports gambling and binge drinking, with individuals who...
Read moreIt’s a dual purpose medicine. A recent study suggests that a drug originally designed to treat cocaine addiction could potentially...
Read moreThe germs are the answer. A recent study reveals that the intricate flavors of a delectable cup of tea are...
Read moreThis is a game-changer. New research suggests that acupuncture could potentially reduce the risk of stroke in individuals with rheumatoid...
Read moreThere is an increase calling for screening this cholesterol. Millions of Americans are unknowingly born with a genetic predisposition to...
Read moreFortify your health with essential vitamins. During the winter months, when sunlight is scarce, obtaining sufficient vitamin D can be...
Read moreNature has a huge impact on mental health. In today's bustling world, the integration of natural elements into architecture and...
Read moreIt’s imperative to reduce the two causes. Recent research in the journal PLOS ONE highlights how individuals facing high blood...
Read moreThis is an amazing discovery. For many, experiencing the flu means feeling unwell for a week or so before symptoms...
Read more